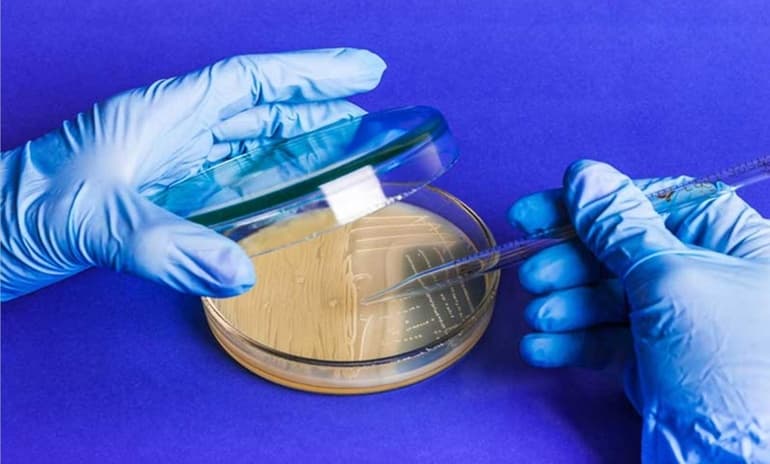
Бесполое размножение &mdash; виды, формы и биологическое значение процесса

Бывает два способа воспроизводства организмов — половое и бесполое размножение. В первом случае происходит слияние гамет, а во втором — развитие из соматической клетки. При воспроизведении потомства с участием единственной не обладающей гаметой (бесполой) особи появившееся на свет растение или животное наследует гены одного родителя, а потому при отсутствии мутации будет являться его точной копией.

Основное определение
Процесс воспроизведения с участием одного родителя отличается от размножения, в котором задействованы две особи. Выделяют следующие особенности бесполого размножения:

- многоклеточный или одноклеточный организм воспроизводится и развивается с помощью митоза;
- в данном процессе мейоз отсутствует;
- число потомства стремительно увеличивается.
Бесполым путем размножаются все организмы с одной клеткой, будь то грибы, многие разновидности растений или многоклеточные простейшие животные. Такой тип размножения существовал задолго до полового вида воспроизводства.
Существуют переходные формы от бесполого воспроизводства к половому:
- партеногенез — особь образуется из гаметы матери;
- гермафродитизм — единственный организм обладает признаками обоих полов.
Существующие виды
Встречается несколько форм бесполого размножения. В таблице отражены следующие виды и их особенности:


Искусственное клонирование
Человек способен получить живой организм бесполым методом искусственным путем. Этот процесс получил название — клонирование. В живой природе такое явление происходит крайне редко. Образец настоящего клонирования в биологии — гомозиготные, или однояйцовые близнецы. Однако они аналогичны только по сравнению между собой и сильно отличаются от родительских особей.

В современном мире способно осуществляться даже клонирование тех особей, которые способны воспроизводить потомство половым способом. Простой пример — известная овечка Долли. Ее клонирование производилось методом переноса ядра соматической клетки родительской особи в донорскую яйцеклетку. По сути, любой вид бесполого воспроизводства будет относиться к клонированию, так как в процедуре участвует соматическая клетка вместо половой, а новый организм идентичен родительской особи.
Что касается растений, в пробирках, колбах и чашках Петри человек получает клетки, аналогичные исходным экземплярам. В основе данной схемы находится тотипотентность клеток. Это свойство подразумевает способность клетки делиться и производить клеточные организмы. Такое явление имеет много преимуществ для человека. Можно взять какую-либо часть растения, будь то корень или стебель, поместить его в необходимую среду, и при благоприятных условиях из основы можно получить новый экземпляр.
Однако понятно, что если взять часть человеческого тела и поместить ее в специальную среду, новой особи не появится. Создание клона животного или человека — крайне сложная процедура. Клональное микроразмножение обладает высочайшим коэффициентом воспроизводства потомства. Благодаря вегетативному размножению способно появляться 10−100 растений за один год, клональное микроразмножение позволяет произвести от 5 тыс. до 1 млн единиц в год. в лабораторных условиях.
Создавать клоны растений крайне выгодно при разведении элитных растений, которых существовало всего лишь несколько экземпляров во всем мире. В США, Голландии, Бельгии, Дании и Польше существуют фирмы, которые специализируются на клонировании растений.
Значение митоза
Митоз — это процесс клеточного деления, в ходе которого из исходной соматической клетки получается две дочерние с аналогичным набором хромосом. Деление происходит в следующие стадии:


Роль митоза крайне важна. Благодаря ему происходит поддержание нужного набора хромосом. Произвести идентичную клетку можно только с помощью этого способа.
Именно по такому принципу происходит обновление клеток эпидермиса и эпителия кишечника. Происходит копирование, а значит, сохранение генетического кода.

С помощью этого метода возможно восстановление частей тела у определенных классов организмов, например, лучи у морской звезды. Митоз обеспечивает размножение бесполым путем, пример — вегетативное воспроизведение растений и почкование у гидр. Митоз отличается от мейоза длительностью фаз и особенностями протекающих в них процессов.
Бесполое размножение значительно отличается от однополого воспроизводства. Первый способ не предполагает присутствие гамет вообще. При партеногенезе (однополом размножении) дочерние клетки образуются из яйцеклетки матери. Что касается бесполого воспроизведения, для одноклеточных организмов свойственно деление, а для многоклеточных — почкование, вегетативное размножение, фрагментация, спорообразование. Бесполым способом происходит воспроизводство у одноклеточных грибов, животных и растений. Этот процесс занимает немного времени и позволяет увеличить численность вида в короткие сроки.